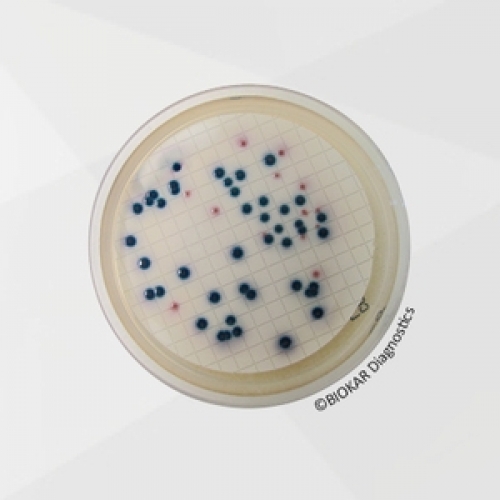

COMPASS® CC Agar
COMPASS® cc Agar allows the direct enumeration of Escherichia coli and coliforms in water by membrane filtration in 24 hours, without the typical confirmation tests as oxidase detection or indole production from tryptophan. COMPASS® cc Agar is adaptable to either water control of treated water and other potable water sources which contain only a small number of bacteria or to much more highly contaminated water sources containing high concentration of interfering bacteria. COMPASS® cc Agar is certified NF VALIDATION under the reference number BKR 23/08-06/12 for the enumeration of E. coli and coliforms in 24 hours in water destined for human consumption.
| Ürün Adı | COMPASS® CC Selective Supplement |
| Ürün Kodu | BS08408 |
| Miktar | 10 vials qsp 500 mL |
TECHNICAL DATA SHEET
TDS_COMPASS CC_BK210_BM153_BS084_ENv5